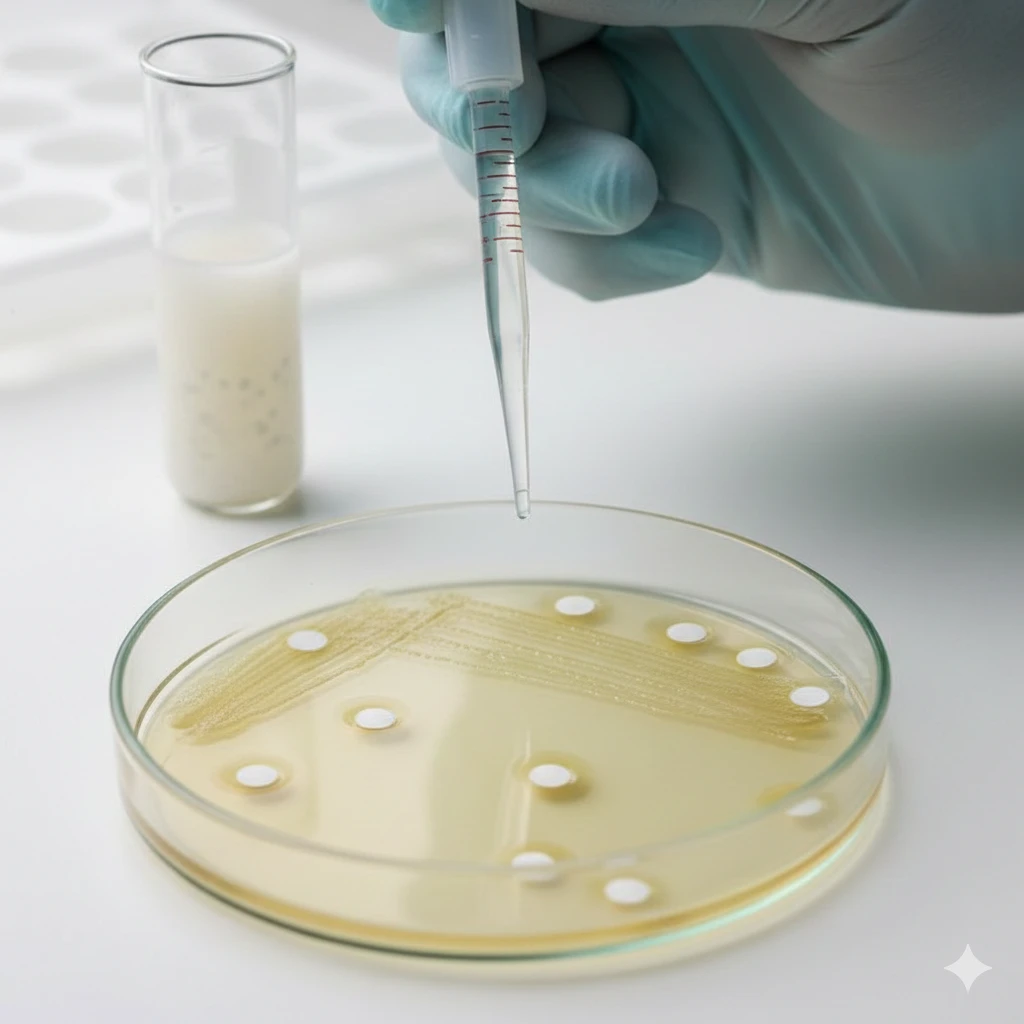
Nipple Discharge Culture and Sensitivity

تفاصيل التحليل
Nipple Discharge Culture and Sensitivity
هل تعانين من إفرازات غير طبيعية من الحلمة؟ هذا التحليل يساعد في تحديد ما إذا كان السبب عدوى بكتيرية أو فطرية. من خلال زراعة العينة واختبار حساسية الميكروبات للمضادات الحيوية، نضمن لك الحصول على تشخيص دقيق وخطة علاج فعالة تستهدف سبب الالتهاب مباشرةً.
الصورة التوضيحية المرتبطة بهذا التحليل